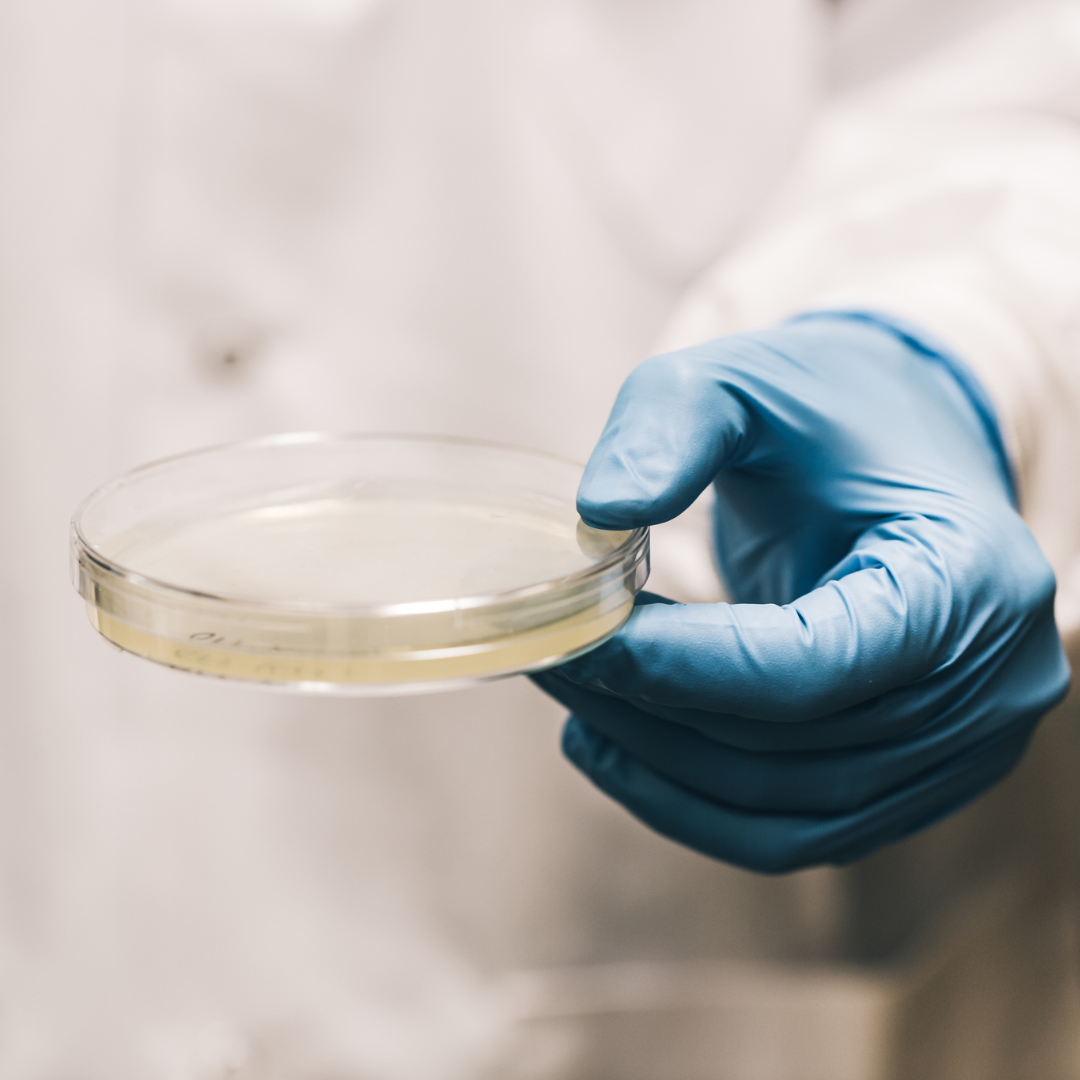

Dental Enzyme Technology
Dental biofilm is a thin, sticky film that forms on the teeth, consisting of bacteria and other microorganisms. It can lead to dental problems such as cavities, gum disease, and bad breath. DentaPrev was developed after years of research to create a protective barrier against the biofilm.

Natural enzyme power
DentaPrev uses enzymes as it is a natural part of all living organisms and strengthens the natural defenses for oral health. DentaPrevs enzyme technology is specifically developed to be effective against biofilm, eneabling the good bacteria to flourish.

Balanced oral flora
The unique blend of enzymes and natural ingredients activates upon use upon contact with saliva in the mouth. This activation process allows your beneficial bacteria to establish themselves. Unlike quick-fix solutions, DentaPrev works on a deeper level to promote long-term health and well-being.

Triple action formula
DentaPrev is used to clean teeth and gums, maintain good oral hygiene, and freshen breath at any time during the day. DentaPrev improves your oral hygiene by creating a multifunctional barrier that cleans and protects.
-
Dental enzyme technology
The enzyme technology of DentaPrev is specifically
developed for the purpose of creating a protective
barrier against harmful bacteria. The result is
improved oral hygiene and well-being in a natural
and effective way. -
Enzyme action
1. Plaque can result in tartar and inflammation
2. DentaPrev is sprayed on the teeth and creates a protective film
3. It provides better oral hygiene with fresher breath
-
Balances the microbiome
-
100% natural ingredients
-
Cleans and protects